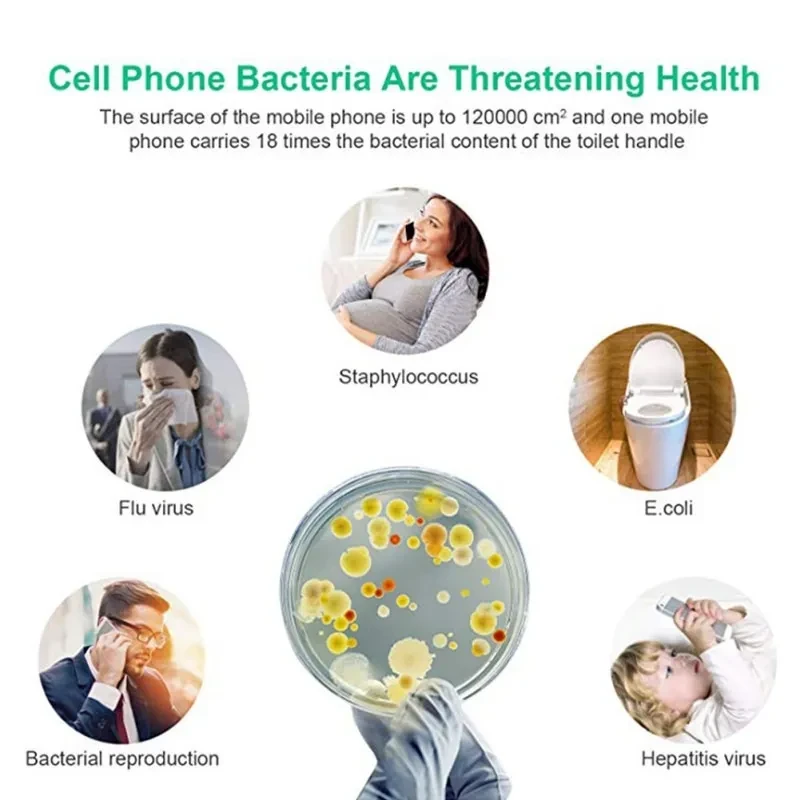
5V Double UV Phone Sterilizer Box

5V Double UV Phone Sterilizer Box
$63.99 AUD
Approx $45.37 USD
Description:
5V Double UV Phone Sterilizer Box: Clean, Sterilize, and Protect Your Devices with Ease
Your Essential Tool for Germ-Free Devices: The 5V Double UV Phone Sterilizer Box
In today’s world, cleanliness and hygiene are more important than ever, especially when it comes to the devices we use daily. From smartphones and headphones to keys and credit cards, our personal items are constantly exposed to bacteria, viruses, and other harmful pathogens. That's where the 5V Double UV Phone Sterilizer Box comes in—a powerful and efficient solution for sanitizing your everyday essentials.
The 5V Double UV Phone Sterilizer Box uses ultraviolet (UV) light technology to disinfect your devices, killing up to 99.9% of bacteria, viruses, and germs. Designed for modern convenience, it can sterilize your phone, earbuds, glasses, keys, and even small personal items in just a few minutes. With the growing demand for hygiene, this device ensures that your gadgets stay safe, clean, and free from harmful germs.
Whether you're looking for a way to sanitize your phone, want to reduce your exposure to bacteria, or simply want peace of mind knowing your belongings are disinfected, the 5V Double UV Phone Sterilizer Box is an essential tool for today’s hygiene-conscious world.
Key Features of the 5V Double UV Phone Sterilizer Box
1. Double UV Light Sterilization for Maximum Efficiency
One of the standout features of the 5V Double UV Phone Sterilizer Box is its dual UV light system. Unlike single UV sanitizers, this box uses two UV-C lamps to provide more thorough coverage and faster sterilization. UV-C light is known for its effectiveness in destroying bacteria and viruses by breaking down their DNA, rendering them harmless. With double the UV coverage, the sterilization process is quicker and more comprehensive, ensuring your items are disinfected from all angles.
2. Wide Compatibility for Various Devices
The 5V Double UV Phone Sterilizer Box isn’t limited to just phones—it’s compatible with a wide range of items, including:
- Smartphones (up to 6.5 inches in size)
- Earbuds and headphones
- Keys and coins
- Glasses and sunglasses
- Face masks
- Remote controls
- Makeup tools and brushes
This versatility means you can sanitize more than just your phone—anything that fits inside the box can be cleaned, making it a great multi-purpose sanitizing tool for your home, office, or on the go.
3. Quick and Efficient Sterilization
The 5V Double UV Phone Sterilizer Box delivers a fast sterilization process, typically taking just 3 to 5 minutes to disinfect your device. This makes it an ideal choice for busy individuals who need a quick and effective way to ensure their devices are germ-free. Whether you're sanitizing your phone during lunch break or just before bed, the short cycle time ensures you don’t waste precious minutes while still achieving a thorough clean.
4. Built-In Wireless Charging Function
To make this sterilizer even more convenient, the 5V Double UV Phone Sterilizer Box also features wireless charging capabilities. Simply place your phone inside the box, and it will not only sanitize your device but also charge it wirelessly. This two-in-one functionality ensures that your phone is ready to use, fully sanitized, and powered up all at once.
The wireless charging function is compatible with all Qi-enabled devices, including many recent models of iPhones, Samsung, and other smartphones. This added feature eliminates the need for multiple devices cluttering your space and streamlines your daily routine.
5. Safe and Chemical-Free Sterilization
UV-C sterilization is a chemical-free process, which means no harsh chemicals or cleaning agents are involved. This makes it a safer, eco-friendly option for disinfecting your devices, particularly for items that come into direct contact with your skin, such as phones and makeup tools. You can feel confident knowing that the sterilization process leaves no residue, fumes, or chemicals behind, making it safe for you and your family.
6. One-Touch Operation for Convenience
The 5V Double UV Phone Sterilizer Box is designed with ease of use in mind. It features a simple one-touch operation that activates the sterilization and charging functions. There’s no complicated setup or multiple buttons to press—just place your device inside, press the button, and let the sterilizer do the work. This makes it ideal for anyone, regardless of technical expertise, to operate.
7. Compact and Portable Design
Designed to be compact and portable, the 5V Double UV Phone Sterilizer Box fits easily on any desk, countertop, or bedside table. Its sleek and modern design ensures it blends seamlessly into your home or office décor. Whether you’re working from home or need to disinfect your devices while traveling, this portable sterilizer box is lightweight and easy to carry.
8. Quiet Operation
The sterilization process runs quietly, so you won’t be disturbed while your devices are disinfecting. Whether you place it in your living room, bedroom, or office, the 5V Double UV Phone Sterilizer Box operates silently, ensuring minimal disruption to your daily routine.
Benefits of the 5V Double UV Phone Sterilizer Box
1. Hygienic and Germ-Free Devices
With constant exposure to germs, your phone and other personal items are breeding grounds for bacteria and viruses. The UV sterilizer box offers an easy and effective way to eliminate these harmful microorganisms, helping to ensure that your devices are hygienic and safe to use.
2. Reduces the Spread of Illness
By sterilizing your phone, keys, and other frequently touched objects, you can reduce the spread of illness-causing bacteria and viruses. Especially in the current health climate, keeping your devices disinfected is an essential part of personal health and wellness.
3. Protects Your Health and Skin
When you use your smartphone or other personal items, germs and bacteria can transfer to your skin, potentially causing irritation, infections, or other health issues. Regular use of the 5V Double UV Phone Sterilizer Box helps protect your skin by ensuring that your devices remain clean and free from harmful pathogens.
4. Eco-Friendly and Safe
Because the 5V Double UV Phone Sterilizer Box uses UV-C light, it is completely free from toxic chemicals, making it a safer option for you and the environment. There’s no need to worry about harmful cleaning agents or sprays—just the natural disinfecting power of UV light.
5. Convenient, All-in-One Design
The dual-purpose design of the 5V UV sterilizer box makes it a practical addition to any home or office. With both sanitization and wireless charging, it eliminates the need for multiple devices or cords cluttering your space. This convenience means you can sanitize and charge your devices in one simple step.
Use Cases for the 5V Double UV Phone Sterilizer Box
1. Home Use
Place the sterilizer box on your kitchen countertop, nightstand, or living room table to disinfect your phone, keys, and other items after you return home. It’s perfect for keeping all of your daily essentials germ-free without the need for chemical cleaners.
2. Office Use
In the office, your phone, desk items, and computer accessories can carry germs from shared spaces. The 5V UV sterilizer box is ideal for sanitizing phones, pens, and even your work ID badge at the start or end of the day. The wireless charging feature also keeps your phone powered up while you work.
3. Travel and On-the-Go
Traveling means exposure to public surfaces, which can carry germs and bacteria. The portable design of this sterilizer box makes it perfect for traveling. Carry it with you to disinfect your phone, earbuds, and other personal items while on the go. Whether you're in a hotel room or at the airport, you’ll always have access to a clean device.
4. Gifts for Health-Conscious Friends and Family
With cleanliness being a top priority for many, the 5V Double UV Phone Sterilizer Box makes for a thoughtful and practical gift. Whether for a birthday, holiday, or special occasion, this device will be appreciated by anyone looking to maintain a clean and hygienic lifestyle.
Why Choose the 5V Double UV Phone Sterilizer Box?
1. Fast and Efficient Sterilization
With the ability to sanitize your devices in as little as 3-5 minutes, this sterilizer box offers a quick and effective solution for cleaning your everyday items.
2. Dual Functionality
The wireless charging feature ensures that your phone is not only cleaned but also charged while it sits inside the sterilizer box.
3. Eco-Friendly and Safe
UV-C light offers a chemical-free sanitization process that is safe for both you and the environment.
4. Portable and Convenient
Its compact design means you can use it at home, in the office, or even while traveling, making it versatile and convenient for various lifestyles.
Overview
If you open the cover during the sterilization process, the sterilizer will automatically stop working.
This product can effectively kill common bacteria such as escherichia coli, candida Albicans, staphylococcus aureus, etc. with high
efficiency of 90%.
There are two ultraviolet germicidal lamps, which are located at the two ends of the sterilizer.
Suitable for disinfection for cell phones with 6.5in, underwear, mask, sock, makeup tools, watches, toothbrushes, jewelry, keys, etc.
Press the 'three flat lines' button to start the ultraviolet sterilization, and after 5 minutes, the sterilization ends, and the indicator
light stays bright during disinfection.
Press the 'three-wave lines' button to start the aroma function, after 10 minutes, the aroma process ends, the indicator light will stay
bright during the process.
Note:
1. Please allow 0-1 inch error due to manual measurement. Thanks for your understanding.
2. Monitors are not calibrated the same, item color displayed in photos may be showing slightly different from the real object. Please take
the real one as standard.
Specifications:
Product name: Sterilizer
Fast charge agreement; QC3.0 agreement
Rated power: 5V / 1A
Product net weight: 300g
Disinfection power: 1W
Product gross weight: 550g
Disinfection time: 5min
Working temperature: -10-45 ℃
Disinfection efficiency; 99.9%
Dimensions: 231 × 127 × 47mm
UV wavelength: 253.7nm
Internal cavity size: 199 × 105 × 30mm
White Style
Specification:
Rated input: Micro5V/1A
Maximum power: 5W
Disinfection power: 2Wx2
Ultraviolet wavelength: 254nm
Operating temperature range: 0 ~ 55 °C
Maximum shape size(LxWxH): 20x11.8x4.5cm/7.87x4.65x1.77\'
Maximum cavity size(LxWxH): 17x9x2.2cm/6.69x3.54x0.87\'
Package Content:
1 * Sterilizer
1 * USB Cable
1 * Cleaning Cloth









.webp)





